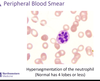

249/250 - Other Anemias (Iron/Chronic Disease, Megaloblastic) Flashcards
(30 cards)
List 3 acquired and 2 hereditary causes of megaloblastic anemia
- Acquired
- B12 deficiency
- B9 (folic acid) deficiency
- Pharmacologic
- Hereditary
- Orotic aciduria
- Lesch-Nyhan syndrome
B9 and B12 deficiency are the most common causes overall
When is it appropriate to use iron to treat anemia of inflammation?
When there is a concurrent iron deficient state
If it’s just anemia of inflammation, don’t sue iron
What findings on peripheral blood smear are indicative of megaloblastic anemia? (3)
- Hypersegmented neutrophils
- Macro-ovalocytes
- Large, oval-shaped blood cells
- Low blood counts overall
How can levels of homocystine and methylmalonate differentiate between folate (B9) vs. B12 deficiency?
-
B9 deficiency
- High homocysteine
- Normal methylmalonate
-
B12 deficiency
- High homocysteine
- High methylmalonate
Both will have megaloblastic anemia; only B12 deficiency will have neurologic sx (subacute combined degeneration)
Is pure dietary deficiency more likely to cause B9 or B12 deficiency?
B9 deficiency
- B9 is found in leafy green vegetables; 3-4 months of body stores*
- B12 is found in meat, eggs, dairy; 2-4 years of body stores => deficiency likely results from malnutrition and malabsorption; look fo other deficiencies*
Describe the pathogenesis of anemia of inflammation (aka anemia of chronic disease)
It all starts with inflammatory stress
- -> Increased hepcidin
- -> Ferroportin is degraded
- -> Iron cannot be absorbed from the GI tract, and it is sequestered as ferrtin
- -> Ferritin increases, but cannot be delivered to erythroid marrow (also, ferritin is an acute phase reactant)
- vs. IDA, where ferritin is reduced
What are the dietary sources of B12?
Meat, eggs, dairy
Body can store 3-4 years => dietary deficiency alone usually does not cause B12 deficiency
How will the following vary in a patient with anemia due to rheumatoid arthritis?
- Iron:
- % saturation:
- Iron binding capacity (IBC or TIBC):
- Ferritin:
- Iron: Low
- % saturation: Low
- Iron binding capacity (IBC or TIBC): Normal
- Ferritin: High
- Inflammatory disease*
- -> Increased hepcidin*
- -> Iron sequestration in storage sites (Ferritin), but cannot be used bc hepcidin is degrading ferroportin*
List 2 clinical scenarios where we would expect hepcidin to be suppressed
Iron deficiency
Hypoxia
What is the first line treatment for hemochromatosis?
Phlebotomy
Only use iron chelation if a pt has concurrent anemia (low hemoglobin), and never use with hereditary hemochromatosis
What CNS manifestation results from B12 deficiency?
Subacute combined degeneration
- Loss of dorsal column, corticospinal tract, spinocerebellar tract
- Decreased sensation, weakness, ataxia
How will the following vary in a patient with hemochromatosis?
- Iron:
- % saturation:
- Iron binding capacity (IBC or TIBC):
- Ferritin:
- Iron: High
- % saturation: High
- Iron binding capacity (IBC or TIBC): Normal or decreased
- Ferritin: High
- Hemochromatosis = defect in hepcidin*
- -> Ferroportin is able to absorb a ton of iron from the gut*
List 4 risk factors for copper deficiency
- Gastric bypass
- Celiac disease
- Excess zinc
- TPN
Presents similarly to bone marrow disease (MDS); rule out before beginning aggressive tx
List 2 clinical scenarios in which we would expect hepcidin to be upregulated
Iron sufficiency/overload
Inflammation (IL-6)
What is the next step in evaluating a patient who has a new iron deficiency anemia?
Rule out bleeding
Then, figure out the underlying disease process
IDA is always caused by an underlying disease or bleeding
Will the bone marrow be hypercellular or hypocellular in B12/folate deficiency?
Hypercellular
Low peripheral blood counts with hypercellular marrow => megaloblastic anemia
What is the most common type of anemia worldwide?
Iron deficiency anemia
What is the treatment for anemia of inflammation?
Treat whatever is causing the inflammation
(Interrupt IL-6 signaling)
Don’t give iron unless there is a concurrent iron-deficiency anemia
Supplementing folate (B9) in vitamin B12 deficiency will improve which symptoms of B12 deficiency?
Hematologic (megaloblastic anemia)
Folate will NOT have any effect on the neurologic symptoms of B12 deficiency!
Will hepcidin be upregulated or downregulated in iron deficiency anemia?
How would this affect ferroportin?
Downregulated hepcidin
- > Ferroportin channel expressed
- Hepcidin puts the brakes on iron absorption by inhibiting iron transport through ferroprotin (Hepcidin causes degradation of ferroportin)*
List 2 functions of ferroportin
Iron transport from hepatocytes -> macrophages
Iron absorption from gut enterocytes -> plasma
Inhibited by hepcidin
What is the difference between absolute and functional iron deficiency anemia?
- Absolute = truly there is not enough iron in the body
-
Functional = Iron is there, but not available for use
- Anemia of inflammation
- Increased EPO (enough iron, but cannot keep up with new demand)
What does % saturation measure? (In terms of iron stores)
Total iron / iron binding capacity
Describe the absorption of B12
- B12 is liberated from binding proteins by gastric acid
- B12 binds salivary haptocorrin (HC)
- B12 released from HC by pancreatec proteases
- B12 binds intrinsic factor (from gastric parietal cells)
- B12-IF complex is absorbed in the ilium
- 3-4 years of body stores; malabsorption is more likely than malnutrition*
- Malabsorption may be caused by low gastric acid, gastric bypass, deficient IF, pancreatic insufficiency, intestinal diseases*

